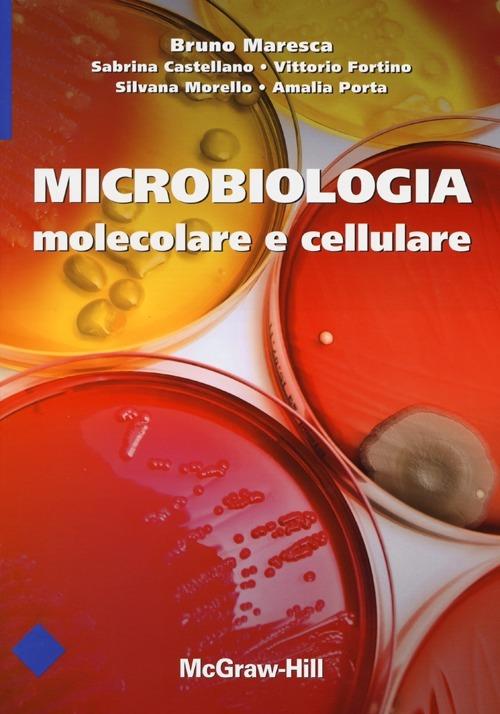
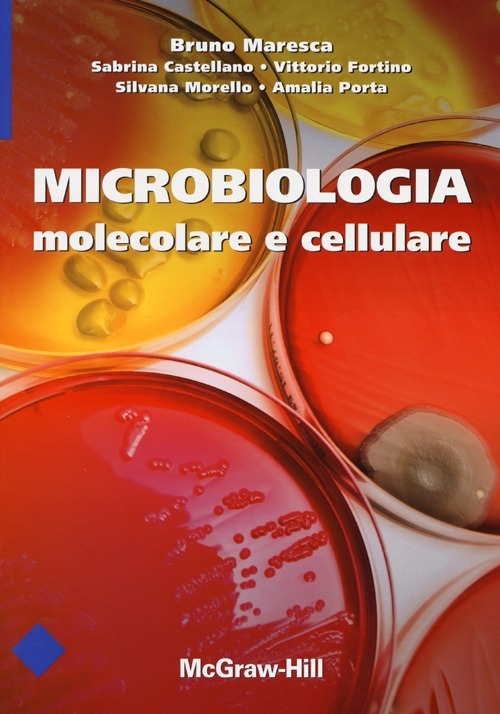

Microbiologia molecolare e cellulare. Ediz. illustrata
Il volume "Microbiologia molecolare e cellulare" si propone di integrare le conoscenze di biologia molecolare, biochimica, genetica e immunologia dei micro-organismi con la comprensione dei meccanismi di patogenicità e interazione ospite/parassita. Lo scopo è che gli studenti da una parte siano al corrente delle attuali conoscenze di microbiologia molecolare e cellulare, dall'altra assimilino le basi per sviluppo biotecnologico di molecole anti-infettive. A conferma dell'approccio multidisciplinare adottato dagli autori, Il testo contiene inoltre un'introduzione a uno dei più importanti campi della ricerca scientifica di oggi, la bioinformatica, applicata in particolare a problematiche di microbiologia.
-
Editore:
-
Collana:
-
Anno edizione:2013
-
In commercio dal:1 febbraio 2013
Le schede prodotto sono aggiornate in conformità al Regolamento UE 988/2023. Laddove ci fossero taluni dati non disponibili per ragioni indipendenti da Feltrinelli, vi informiamo che stiamo compiendo ogni ragionevole sforzo per inserirli. Vi invitiamo a controllare periodicamente il sito www.lafeltrinelli.it per eventuali novità e aggiornamenti.
Per le vendite di prodotti da terze parti, ciascun venditore si assume la piena e diretta responsabilità per la commercializzazione del prodotto e per la sua conformità al Regolamento UE 988/2023, nonché alle normative nazionali ed europee vigenti.
Per informazioni sulla sicurezza dei prodotti, contattare productsafety@feltrinelli.it